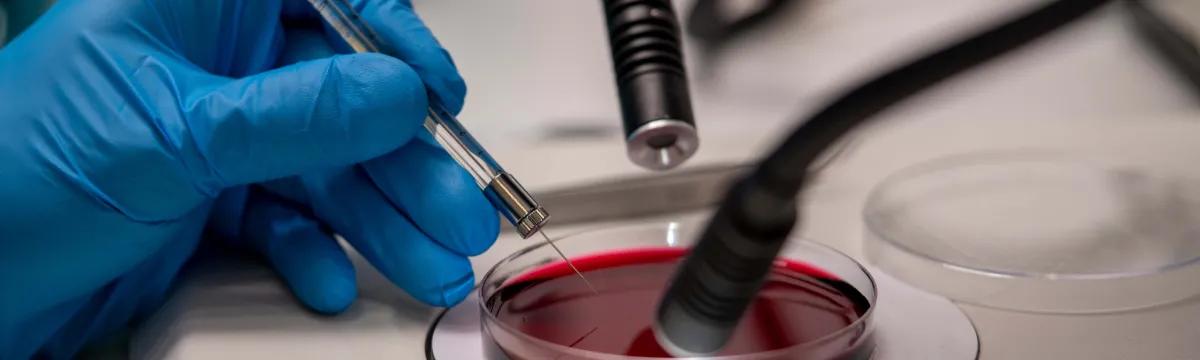
Clear Vision Research Lab

Collaborate with us
ANU fosters impactful partnerships with industry and government, driving tangible outcomes. From research collaborations and government-funded projects to executive education and broader engagement, our diverse collaborative opportunities connect organisations with the University’s expertise and networks.
How collaboration works
It is through our strategic collaborations with external organisations that we drive forward our mission of unravelling the mysteries of diseases impacting our society.
Contact
Soumi Bala
School Manager
+61 2 6125 6046
jcsmr.sm@anu.edu.au
Engage with us
Contact a Course Advisor Make an enquiry
Plan a visit Give to ANU
Image

